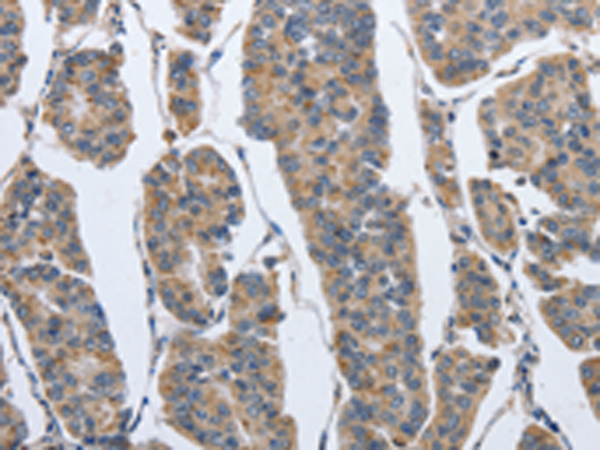

别名:Imp7; RANBP7应用:WB,IHC
反应种属:Human, Mouse
规格:50μl/100μl
| Description |
|---|
| The importin-alpha/beta complex and the GTPase Ran mediate nuclear import of proteins with a classical nuclear localization signal. The protein encoded by this gene is a member of a class of approximately 20 potential Ran targets that share a sequence motif related to the Ran-binding site of importin-beta. Similar to importin-beta, this protein prevents the activation of Ran’s GTPase by RanGAP1 and inhibits nucleotide exchange on RanGTP, and also binds directly to nuclear pore complexes where it competes for binding sites with importin-beta and transportin. This protein has a Ran-dependent transport cycle and it can cross the nuclear envelope rapidly and in both directions. At least four importin beta-like transport receptors, namely importin beta itself, transportin, RanBP5 and RanBP7, directly bind and import ribosomal proteins. |
| Specification | |
|---|---|
| Aliases | Imp7; RANBP7 |
| Swissprot | O95373 |
| WB Predicted band size | 120 kDa |
| Host/Isotype | Rabbit IgG |
| Storage | Store at 4°C short term. Aliquot and store at -20°C long term. Avoid freeze/thaw cycles. |
| Species Reactivity | Human, Mouse |
| Immunogen | Synthetic peptide of human IPO7 |
| Formulation | pH7.4 PBS, 0.05% NaN3, 40% Glycerol |
| Application | |
|---|---|
| WB | 1/500-1/2000 |
| IHC | 1/100-1/300 |
| ELISA | 1/2000-1/5000 |
 |
Gel: 6%SDS-PAGE, Lysate: 40 μg, Lane: Hela cells, Primary antibody: P04971(IPO7 Antibody) at dilution 1/300, Secondary antibody: Goat anti rabbit IgG at 1/8000 dilution, Exposure time: 5 minutes |
 |
The image is immunohistochemistry of paraffin-embedded Human gasrtic cancer tissue using P04971(IPO7 Antibody) at dilution 1/40. (Original magnification: ×200) |
|
The image is immunohistochemistry of paraffin-embedded Human breast cancer tissue using P04971(IPO7 Antibody) at dilution 1/40. (Original magnification: ×200) |
本公司的所有产品仅用于科学研究或者工业应用等非医疗目的,不可用于人类或动物的临床诊断或治疗,非药用,非食用。
暂无评论
本公司的所有产品仅用于科学研究或者工业应用等非医疗目的,不可用于人类或动物的临床诊断或治疗,非药用,非食用。
 中文
中文 








发表回复